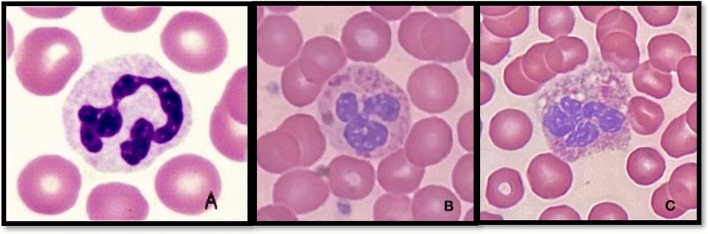
PMC11079053 – Fig1
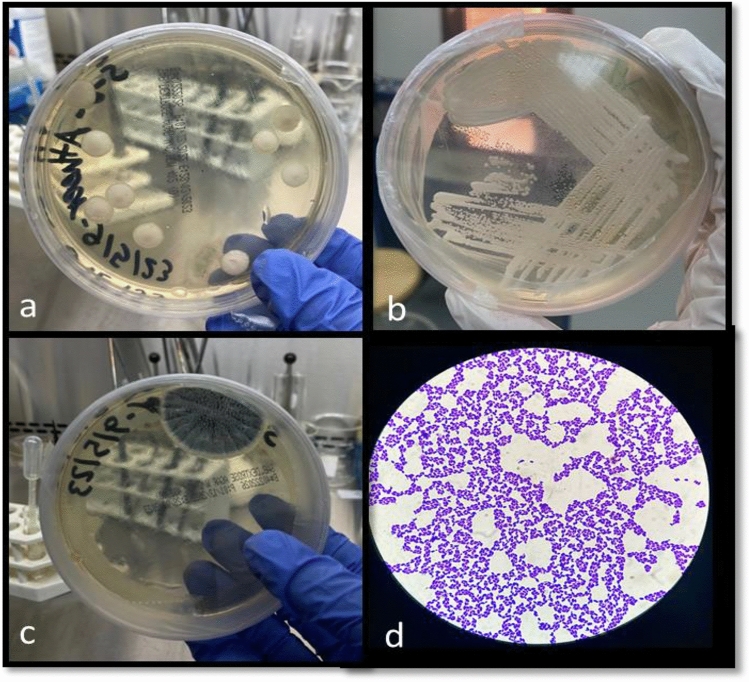
PMC11079053 – Fig2

Evaluation of the immune system status and hematological dyscrasias, among amphetamine and cannabis abusers at Eradah Hospital in Qassim, Saudi Arabia
Abstract
This cross-sectional study aims to evaluate the immune system status and hematological disturbances among individuals who abuse amphetamines and cannabis. Substance abuse, particularly of amphetamines and cannabis, has been associated with various adverse effects on the body, including potential impacts on the immune system and hematological parameters. However, limited research has been conducted to comprehensively assess these effects in a cross-sectional design. Additionally, fungal infections are on the rise internationally, and immune-compromised people are particularly susceptible. The study will recruit a sample of amphetamine and cannabis abusers (n = 50) at the Eradah Hospital in the Qassim Region of Buraydah and assess their sociodemographic and biochemical variables, including blood indices and differential WBC indices, liver, and kidney profiles. Additionally, 50 sputum samples in total were cultured for testing for fungus infections. To obtain the descriptive statistics, the data was imported into Microsoft Excel and subjected to statistical analysis using SPSS 22.0. Amphetamine and cannabis abuser’s sociodemographic variables analysis observed that the majority (52%) were aged 18–30, with 56% in secondary school. Unemployment was a significant issue, and most had no other health issues. The majority (50%) had 5–10 years of abuse, while 32% had less than 5 years, and only 18% had been drug abusers for more than 10 years. There were significant changes (p < 0.001) in all different leukocyte blood cells, including neutrophils, lymphocytes, monocytes, eosinophils, and basophils. Furthermore, a microscopic examination of blood films from individuals who misuse the combination of the medications "amphetamine and cannabis" reveals hazardous alterations in Neutrophils. Out of 50, 35 sputum samples showed positive growth on Sabouraud dextrose agar (SDA) with chloramphenicol antibiotic, indicating a unicellular fungal growth. The present study explores the immune system and hematological disturbances linked to amphetamine and cannabis abuse, providing insights into health risks and targeted interventions. The findings complement previous research on drug users’ hematological abnormalities, particularly in white blood cells. Routine hematological tests help identify alterations in homeostatic conditions, improving patient knowledge and preventing major issues. Further research is needed on multi-drug abuse prevention, early detection, and intervention. The cross-sectional design allows for a snapshot of the immune system and hematological status among abusers, laying the groundwork for future longitudinal studies. Key Words: Drug Effect, Immunity, Epidemiology, Oxidative Stress, Inflammation.
Article type: Research Article
Keywords: Amphetamine, Cannabis, Immune system, Fungal infection, Toxicology, Immunology, Microbiology
Affiliations: https://ror.org/01wsfe280grid.412602.30000 0000 9421 8094Department of Medical Laboratories, College of Applied Medical Sciences, Qassim University, 51452 Buraydah, Saudi Arabia; https://ror.org/053g6we49grid.31451.320000 0001 2158 2757Medical Biochemistry and Molecular Biology, Faculty of Medicine, Zagazig University, Zagazig, Egypt; https://ror.org/01wsfe280grid.412602.30000 0000 9421 8094Department of Basic Health Sciences, College of Applied Medical Sciences, Qassim University, 51452 Buraydah, Saudi Arabia; Director Laboratory Department, MOH-KSA, Erada Mental Health Hospital, Buraydah, Qassim Saudi Arabia; https://ror.org/053g6we49grid.31451.320000 0001 2158 2757Faculty of Medicine, Zagazig University, Zagazig, Egypt; https://ror.org/056zv5g90grid.411910.c0000 0001 0371 7646Department of Biochemistry, Jinnah University for Women, Karachi, 74600 Pakistan
License: © The Author(s) 2024 CC BY 4.0 Open Access This article is licensed under a Creative Commons Attribution 4.0 International License, which permits use, sharing, adaptation, distribution and reproduction in any medium or format, as long as you give appropriate credit to the original author(s) and the source, provide a link to the Creative Commons licence, and indicate if changes were made. The images or other third party material in this article are included in the article’s Creative Commons licence, unless indicated otherwise in a credit line to the material. If material is not included in the article’s Creative Commons licence and your intended use is not permitted by statutory regulation or exceeds the permitted use, you will need to obtain permission directly from the copyright holder. To view a copy of this licence, visit http://creativecommons.org/licenses/by/4.0/.
Article links: DOI: 10.1038/s41598-024-61182-4 | PubMed: 38719969 | PMC: PMC11079053
Relevance: Moderate: mentioned 3+ times in text
Full text: PDF (1.4 MB)
Introduction
Amphetamine and cannabis abuse are an alarming issue worldwide, with significant implications for public health. Addiction negatively impacts individuals and society, leading to crimes. Saudi Arabia’s General Directorate for Drug Control combats addiction by swiftly implementing measures, controlling smugglers, and raising awareness among citizens, particularly young people, about the harms of drugs1.
Important medications with stimulant and anxiolytic properties frequently are misused or overused, which has been linked to serious side effects, and higher mortality and morbidity rates around the world, and severe side effects. Cannabis and amphetamine are two narcotics that are frequently combined, and addiction to both drugs has risen globally, especially in Saudi Arabia2. In addition, a study in Jazan, Saudi Arabia found that the number of fatalities related to amphetamine addiction and other narcotics substances increased from 18 to 80% between 2018 and 20203, but in the Qassim region, cannabis addiction was the most prevalent drug usage, followed by amphetamine2.
These substances have psychoactive properties and are commonly used for recreational purposes. However, their abuse can lead to various adverse effects on the body, including disturbances in blood indices, liver function, and kidney profile. Understanding the impact of amphetamine and cannabis abuse on these physiological parameters is crucial for assessing the overall health risks associated with substance abuse. Amphetamine and cannabis abuse have been linked to alterations in blood indices. Studies have reported changes in red blood cell count, white blood cell count, and platelet count among individuals who abuse these substances4,5. These alterations can have implications for overall blood health and may increase the risk of hematological disorders.
The liver plays a vital role in metabolizing drugs and toxins, including amphetamines and cannabis. Prolonged abuse of these substances can lead to liver damage and dysfunction. Elevated liver enzymes, such as alanine aminotransferase (ALT) and aspartate aminotransferase (AST), have been observed in individuals with amphetamine and cannabis abuse2,6. These findings suggest potential hepatotoxic effects associated with substance abuse.
Amphetamine and cannabis abuse have been associated with renal dysfunction and impaired kidney function. Studies have reported increased levels of serum creatinine and blood urea nitrogen (BUN) in individuals who abuse these substances7,8. These findings indicate potential nephrotoxic effects associated with substance abuse. Chronic amphetamine abuse disrupts the release of cytokines in microglial cells, causing inflammation and suppressing immune responses. This can lead to liver function changes. Studies have shown a significant reduction in serum immunoglobulin levels among amphetamine abusers, potentially causing immunodeficiency with recurrent infections9,10.
In addition, another study found that there is leukopenia including granulocyte and monocyte, induced by prolonged psychostimulant treatment. Recently studies indicate amphetamine stands for impact on both innate and adaptive immune systems and amphetamine abusers will stay immunocompromised even after treatment11.
Cannabis abuse can cause health issues like respiratory complications, immune system dysfunction, and increased infection susceptibility. Tetrahydrocannabinol, a widely studied cannabinoid, is responsible for most effects through brain-specific receptors. Marijuana, derived from Cannabis sativa leaves, contains significant quantities of THC, which is responsible for mental state effects among users12. Furthermore, cannabis has neurological impacts and alters cytokine levels, triggering immune modulation. It reduces pro-inflammatory cytokines and raises anti-inflammatory ones. Maternal exposure to cannabis during pregnancy can cause dysregulation of the fetus’s innate and adaptive immune systems, weakening its defense against infections and cancers13,14.
Oxidative stress is a biological imbalance resulting from the excess production and accumulation of oxygen-reactive species (ROS) in cells and tissues, which can cause cell and tissue damage due to environmental stressors and xenobiotics. Caused by drug-induced damage to vital organs like the liver, kidney, cardiovascular, and nervous systems, results from mitochondrial dysfunction and dopamine oxidation. This leads to deterioration of cell components and a pro-apoptotic response. Abusers of amphetamine and cannabis increase serum oxidative stress biomarkers, disrupting immune system functions, and leading to infections and inflammation15–17.
Primarily, most labs test for substances that are often abused. Depending on the drug and the mode of delivery, blood tests can be used to identify drug use18. Furthermore, there is a growing focus on the hematological abnormalities that substance addicts experience, which may have serious medical repercussions. There are direct hematological adverse effects of acute and chronic drug abuse, including toxic effects on bone marrow or other blood-forming organs, leading to lower-than-normal or malfunctioning blood cells. Indirect effects may lead to alterations in metabolic and/or physiological functions, which determine liver and kidney diseases, and nutritional deficiencies, that affect the function of various blood cells19,20.
Factors contributing to the increase in fungal infections include aging immunity, pulmonary diseases, and immunosuppressive regimes. The World Health Organization (WHO) has published a list of nineteen fungal priority pathogens, highlighting high-risk diseases. However, less is known about newer risk factors, and misdiagnosis and poor understanding by healthcare providers make it difficult to determine the global burden, leading to potentially more infected people than currently believed21.
This cross-sectional study aims to evaluate amphetamine and cannabis drug-related toxicity in immunocompromised drug users by measuring different biochemical parameters such as the blood indices, differential WBCs indices, and liver and kidney profiles. Also, susceptibility and prevalence of fungal infections, among these drug abusers particularly in the Qassim region, KSA.
Methodology
Study design and participants
A cross-sectional study was carried out at the Eradah Hospital in Qassim, Saudi Arabia. Volunteer sampling techniques were employed to recruit Saudi males and females aged 18 years or older who abuse cannabis and amphetamines. This study aims to gather samples from 50 participants, according to the DSM-V criteria for drug abuse, describing the continued use of cannabis despite impairment in psychological, physical, or social functioning. Inclusion criteria encompass Saudi female and male participants aged 18 or above who consent to participate. Exclusion criteria involve non-Saudi individuals, participants under 18 years old, and those who decline participation.
Informed consent
Each participant’s permission was also sought after being informed of the full scope of the study’s goals and the procedures used to collect the samples. However, the participant’s informed consent was obtained with the doctor’s supervision, and the information gathered was kept confidential and used solely for study.
Sample size calculation
The sample size estimation for a cross-sectional study with one group is calculated using the formula: n = Z^2 (1 − a/2) × P (1 − P)/d^2. Here, n represents the sample size, Z^2 (1 − a/2) is the confidence interval (1.65 for 95% confidence), P is the estimated proportion (0.041 for the proportion of individuals abusing cannabis and amphetamines), and d is the desired precision (0.05). Plugging in the values, we get n = 1.65^2 × 0.041 (1–0.041)/0.05^2, which simplifies to n = 2.7225 × 0.0393/0.0025. Further simplification yields n = 0.107/0.0025, resulting in n = 42.8. Therefore, the estimated number of research participants is approximately 43 individuals who abuse cannabis and amphetamines. Rounded up, this suggests a sample size of fifty participants.
Sample collection and biochemical analysis
Three ml of whole blood samples were taken in Ethylenediaminetetraacetic acid (EDTA) tubes, which were drawn by the nurses in the hospital to measure the Complete Blood Count (CBC) with blood differential by “Sysmex xn series” for these parameters (WBC, RBC, HB, HCT, MCV, MCH, MCHC, PLT, NE, LYM, MON, EO, BASO), and then also blood film observed under a microscope (Light microscope (OLYMPUS), to look at leukocyte cell structure. The prepared blood films were stained with 10% Giemsa stain for 10 min after completion of fixation by methanol. Additionally, the “Dimension & Cobas” (Roche, Switzerland) machine used blood samples in a heparin tube for testing ALT, AST, ALP, Creatinine, and BUN to check the kidney and liver functions among participants. Before being processed in automated analyzers, the blood samples underwent centrifugation (1500 rpm for 10 min) to separate their constituents, yielding clear plasma for precise and reliable results. The conducted tests were executed in strict compliance with established quality control standards, encompassing the calibration and maintenance procedures of utilized equipment to uphold precision and reliability in the obtained results. Furthermore, adherence to laboratory safety protocols was maintained, along with the sustenance of a hygienic and systematically arranged operational setting. After the observation and collection of results, appropriate disposal measures were undertaken, with all samples handled with precision. Contaminated cultures and pipettes were specifically disposed of in impermeable red bag containers bearing biohazard symbols to ensure proper containment.
To quantify immunological function in amphetamine and cannabis users and screen the sample for fungal infections, the study calls for the collection of sputum samples. Participants cough up sputum samples from deep within the chest into a sterile plastic collection bottle, which are then cultivated on Sabouraud dextrose agar with Chloramphenicol, at 25 °C for one week of incubation in a hospital microbiology lab. After incubation, fungi were identified through macroscopic examination by observing the colony morphology, color, texture, and growth pattern which provide initial clues about the fungi present. Further, the microscopic examination was conducted using a stain (Crystal violet), to analyze the fungal structures. Before commencing a culture, the suitability of a sputum sample for fungal analysis was substantiated, ensuring it exhibits purulent characteristics indicative of lower respiratory tract origin and contains a sufficient quantity for culturing purposes, while also being free from saliva contamination.
Statistical analysis
Microsoft Excel 2023 was used to input, tabulate, and analyze the gathered data. The quantity and percentage of categorical variables were determined to apply the descriptive analysis. To handle and analyze more data, the SPSS 22.0 application was used. The measured data distribution was represented by mean ± SD. The investigation of the link among the different factors was conducted by basic correlation analysis. The ANOVA test was employed to examine the average difference between the two groups under investigation. When the P value is less than 0.05, the correlation and difference between variables are deemed statistically significant.
Ethical considerations
Study approval was obtained from the Regional Research Ethics Committee, Registered at the National Committee of Bio & Med. Ethics [NCBE] Registration No. H-04-Q-001. Participants were allowed to provide informed consent before sample collection and were briefed on the study’s objectives. Each participant completed informed consent forms, explicitly acknowledging their ability to withdraw from participation at any given time. Strict confidentiality measures were implemented to protect the dataset for research purposes only, ensuring participant anonymity by omitting sensitive identifiers such as names and addresses. All methods were performed according to the relevant guidelines and regulations, particularly with the Declaration of Helsinki, which states the ethical standards for medical research involving human beings.
Potential biases and limitations
In this cross-sectional study with a volunteer sampling technique, both sampling bias and confounding variables presented challenges. Participants self-selected, potentially distorting the population’s view by overrepresenting or excluding certain groups. Additionally, confounding variables made it difficult to accurately attribute observed associations, limiting the study’s ability to draw meaningful conclusions about cause and effect due to the lack of random assignment or control.
Results
The sociodemographic variables of the 50 amphetamine and cannabis abusers’ participants were included in this study (Table 1). For age, it is noticed that the majority, about half (52%), were 18–30 years of age, fewer (36%) were 31–40 years of age, and only 12% were above the age of 41 years. Most of the abusers (56%) are in secondary school-level education; a few (14%) were in preparatory school, and a few (4%) were in elementary school, whereas 26 percent were college-educated. In addition, only 24% of abusers answered that they have other health issues, and 76% answered no. The data collected from the abusers about the number of years of addiction shows the following: 32% are less than 5 years, 50% are from 5 to 10 years, and 18% are more than 10 years. Whereas 92% of the abusers are unemployed and 8% are employed.
Table 1: Distribution of Cannabis and Amphetamine abusers based on their demographic characteristics.
| Demographic variables | Cannabis and amphetamine | |
|---|---|---|
| Count | % | |
| Age | ||
| 18–30 | 26 | 52 |
| 31–40 | 18 | 36 |
| 41 and above | 6 | 12 |
| Educational level | ||
| Elementary school | 2 | 4 |
| Preparatory school | 7 | 14 |
| Secondary school | 28 | 56 |
| College grade | 13 | 26 |
| Other health issues | ||
| No | 38 | 76 |
| Yes | 12 | 24 |
| Duration of abuse | ||
| Less than 5 years | 16 | 32 |
| From 5 to 10 years | 25 | 50 |
| More than 10 years | 9 | 18 |
| Employee | ||
| No | 46 | 92 |
| Yes | 4 | 8 |
Table 2 presents a comprehensive hematological analysis of amphetamine and cannabis abusers (n = 50). For this study, the analysis of various blood cell counts and indices means, standard deviations, t-tests, and p values for hypothesis testing between the “normal” and “non-normal” groups. For instance, “Norm” which means normal range or values, and “Non-Norm” which means abnormal values to compare the biochemical parameters. The findings provide valuable insights into the distribution and significance of blood parameters between normal and non-normal categories, contributing to our understanding of the physiological variations in these parameters.
Table 2: Complete Blood Count (CBC) analyzed results for Cannabis and Amphetamine abusers.
| Blood indices | N | Mean | SD | Categories | N | Mean | SD | Student’s t-test | p |
|---|---|---|---|---|---|---|---|---|---|
| RBC | 50 | 5.07 | 0.44 | Norm | 50 | 5.0684 | 0.44422 | – | – |
| 4–6.5 | Non-norm | 0 | . | . | |||||
| HB | 50 | 14.63 | 1.28 | Norm | 45 | 14.8844 | 1.0514 | 5.236 | 0.001 |
| 13–17 | Non-norm | 5 | 12.34 | 0.77006 | |||||
| HCT | 50 | 44.24 | 3.53 | Norm | 46 | 44.6109 | 2.74066 | 1.131 | 0.339 |
| 37–52 | Non-norm | 4 | 40.025 | 8.07026 | |||||
| MCV | 50 | 87.18 | 4.68 | Norm | 47 | 88.0426 | 3.15407 | 7.637 | 0.001 |
| 78–95 | Non-norm | 3 | 73.6 | 3.63868 | |||||
| MCH | 50 | 29.03 | 1.93 | Norm | 47 | 29.4128 | 1.19357 | 9.072 | 0.001 |
| 26–32 | Non-norm | 3 | 23.0333 | 0.83865 | |||||
| MCHC | 50 | 33.34 | 1.05 | Norm | 44 | 33.5909 | 0.82682 | 5.983 | 0.001 |
| 32–36 | Non-norm | 6 | 31.5 | 0.55857 | |||||
| PLT | 50 | 252.24 | 51.33 | Norm | 49 | 254.49 | 49.3048 | 2.259 | 0.028 |
| 150–450 | Non-norm | 1 | 142 | . | |||||
| WBC | 50 | 7.55 | 1.82 | Norm | 47 | 7.3049 | 1.57759 | − 16.213 | 0.001 |
| 4–10 | Non-norm | 3 | 11.3967 | 0.17954 | |||||
| NE | 50 | 2.93 | 1.33 | Norm | 39 | 3.2741 | 1.2787 | 7.182 | 0.001 |
| 2–7.5 | Non-norm | 11 | 1.6709 | 0.29484 | |||||
| LYM | 50 | 2.81 | 0.98 | Norm | 37 | 3.2241 | 0.77231 | 11.617 | 0.001 |
| 2–7.5 | Non-norm | 13 | 1.6185 | 0.19693 | |||||
| MON | 50 | 0.73 | 0.39 | Norm | 42 | 0.5988 | 0.1766 | − 4.569 | 0.002 |
| 0.2–1 | Non-norm | 8 | 1.4063 | 0.49387 | |||||
| EO | 50 | 0.25 | 0.17 | Norm | 14 | 0.4814 | 0.11786 | 9.388 | 0.001 |
| 0.3–1 | Non-norm | 36 | 0.1636 | 0.07442 | |||||
| BASO | 50 | 0.04 | 0.02 | Norm | 2 | 0.1 | 0 | 4.689 | 0.001 |
| 0.1–0.3 | Non-norm | 48 | 0.0342 | 0.01966 |
*Significance, if present, is in favor of the category with the highest arithmetic mean, **Correlation is significant at p < 0.001.
Our study also shows significant changes in different white blood cell types, including neutrophils (NE; p value = 0.001), lymphocytes (LYM; p value = 0.001), monocytes (MON; p-value = 0.002), eosinophils (EO; p value = 0.001), and basophils (BASO; p value = 0.001), suggesting immune system disorder. Whereas, there are no significant changes for RBC, HCT, RBC indices, or PLT (Table 2).
The study’s most startling discovery is that amphetamine and cannabis abusers’ peripheral blood smears frequently exhibit neutrophil cytotoxicity. We can interpret white blood cell properties (size, shape, and color) by looking into peripheral blood films. Panel A displays the typical features, while Panels B and C display harmful alterations (Fig. 1). During differential counting, the neutrophil showed cytotoxic impact, including nuclear crumbling, vacuolization, and defragmentation, which may suggest the impact of drug abuse involving some cytotoxic metabolites such as free radicals, ROS- reactive oxygen species, and cytokines, and specifically the vacuolization in neutrophils is strongly representative of infection.
The study analyzed the impact of cannabis and amphetamine addiction on the liver and renal profiles (Table 3). Results showed a significant positive link between years of abuse and the liver profile (ALT-GPT), with a correlation coefficient of r = 0.453. The study also found a significant effect of years of abuse on ALT-GPT, accounting for 21% of the variation. The data also showed a positive relationship between years of abuse and AST-GOT, with a correlation coefficient of r = 0.641, suggesting that abuse over years accounts for 41% of the variation in AST-GOT. However, there was no statistically significant effect of years of misuse on alkaline phosphatase, with a p > 0.196.
Table 3: Simple linear regression analysis test of the effect of the number of years of Amphetamines and Cannabis abuse on different parameters of LFTs, and KFTs profile.
| No. of years of drug abuse | B (beta) | (F) | p value | Correlation (R) | Coefficient of determination (R2) |
|---|---|---|---|---|---|
| ALT-GPT | 1.848 | 12.387 | 0.001 | 0.453 | 0.205 |
| AST-GOT | 1.574 | 33.448 | 0.001 | 0.641 | 0.411 |
| ALP | 0.488 | 1.719 | 0.196 | 0.186 | 0.035 |
| Creatinine | 0.711 | 6.95 | 0.011 | 0.356 | 0.121 |
| BUN | 0.081 | 6.637 | 0.013 | 0.349 | 0.121 |
ALT-GPT alanine aminotransferase-glutamic pyruvic transaminase, AST-GOT aspartate aminotransferase-glutamic oxaloacetic transaminase, ALP alkaline phosphatase, BUN blood urea nitrogen.
*Correlation is significant at p < 0.001.
Furthermore, there is a statistically significant and positive correlation between creatinine and BUN and several years of abuse. At a significance threshold of α ≤ 0.05, the correlation coefficient of 0.356 indicates that years of abuse had a substantial impact on creatinine. The p > 0.011, and the coefficient of determination (r2) is 0.121. This implies that 12% of the fluctuation in creatinine over the years can be attributed to drug misuse. Additionally, the study demonstrates a substantial influence on both variables and a positive correlation between the number of years of abuse and BUN.
To check differences in patients who take the two types of drugs and demographic variables, an ANOVA test has been used, where the null hypothesis refers to the fact that there are no significant differences in patients who take the two types of drugs and demographic variables represented in Table 4. There were established significant differences in MONO related to the age variable and blood variables, where the p-value of the test was 0.035 less than 0.05. Whereas, other significant differences were established in ALT-GPT and AST-GOT related to age variables and liver variables, where the p-values of these tests were 0.000 and 0.001, respectively. Therefore, the results conclude that the age variable affects the emergence and rate of the impact of drug abuse. However, this correlation does not imply causation, meaning it only refers to the variables solely based on an observed association or correlation between them. Additionally, there are no significant differences in other demographic variables correlated with blood variables, liver variables, or kidney variables.
Table 4: Correlation analysis of Age variables with CBC, LFTs, and KFTs in Cannabis and Amphetamine abusers.
| Variables | Age (years) | N | Mean | Std. Dev | F | Sig* |
|---|---|---|---|---|---|---|
| WBC | 18–30 | 26 | 7.606 | 2.032 | 0.358 | 0.701 |
| 31–40 | 18 | 7.313 | 1.778 | |||
| 41 and above | 6 | 8.022 | 0.681 | |||
| RBC | 18–30 | 26 | 5.072 | 0.434 | 0.303 | 0.740 |
| 31–40 | 18 | 5.023 | 0.487 | |||
| 41 and above | 6 | 5.188 | 0.404 | |||
| HGB | 18–30 | 26 | 14.788 | 1.079 | 0.692 | 0.505 |
| 31–40 | 18 | 14.344 | 1.585 | |||
| 41 and above | 6 | 14.800 | 1.101 | |||
| HCT | 18–30 | 26 | 44.535 | 3.174 | 0.519 | 0.599 |
| 31–40 | 18 | 43.583 | 4.398 | |||
| 41 and above | 6 | 44.967 | 1.838 | |||
| MCV | 18–30 | 26 | 87.142 | 4.656 | 0.005 | 0.995 |
| 31–40 | 18 | 87.261 | 3.123 | |||
| 41 and above | 6 | 87.067 | 8.535 | |||
| MCH | 18–30 | 26 | 29.162 | 1.845 | 0.181 | 0.835 |
| 31–40 | 18 | 28.967 | 1.689 | |||
| 41 and above | 6 | 28.650 | 3.055 | |||
| MCHC | 18–30 | 26 | 33.485 | 0.810 | 0.585 | 0.561 |
| 31–40 | 18 | 33.233 | 1.213 | |||
| 41 and above | 6 | 33.033 | 1.503 | |||
| PLT | 18–30 | 26 | 245.038 | 40.087 | 0.768 | 0.470 |
| 31–40 | 18 | 255.833 | 53.481 | |||
| 41 and above | 6 | 272.667 | 85.092 | |||
| NE# | 18–30 | 25 | 3.285 | 1.673 | 1.895 | 0.162 |
| 31–40 | 18 | 2.602 | 0.733 | |||
| 41 and above | 6 | 2.452 | 0.640 | |||
| LYM# | 18–30 | 26 | 2.788 | 0.978 | 0.215 | 0.807 |
| 31–40 | 18 | 2.752 | 1.031 | |||
| 41 and above | 6 | 3.052 | 0.933 | |||
| MONO# | 18–30 | 26 | 0.605 | 0.194 | 3.592 | 0.035* |
| 31–40 | 18 | 0.813 | 0.515 | |||
| 41 and above | 6 | 1.003 | 0.436 | |||
| EO# | 18–30 | 26 | 0.258 | 0.167 | 0.837 | 0.439 |
| 31–40 | 18 | 0.222 | 0.155 | |||
| 41 and above | 6 | 0.323 | 0.218 | |||
| BASO# | 18–30 | 26 | 0.038 | 0.022 | 0.361 | 0.699 |
| 31–40 | 18 | 0.033 | 0.025 | |||
| 41 and above | 6 | 0.042 | 0.026 | |||
| ALT-GPT | 18–30 | 26 | 2.00 | 0.000 | 20.680 | 0.000* |
| 31–40 | 18 | 2.00 | 0.000 | |||
| 41 and above | 6 | 2.50 | 0.548 | |||
| AST-GOT | 18–30 | 26 | 1.69 | 0.471 | 8.778 | 0.001* |
| 31–40 | 18 | 2.00 | 0.485 | |||
| 41 and above | 6 | 2.67 | 0.816 | |||
| ALP | 18–30 | 26 | 2.00 | 0.000 | ||
| 31–40 | 18 | 2.00 | 0.000 | |||
| 41 and above | 6 | 2.00 | 0.000 | |||
| CREATININE | 18–30 | 26 | 1.96 | 0.196 | 0.451 | 0.640 |
| 31–40 | 18 | 2.00 | 0.000 | |||
| 41 and above | 6 | 2.00 | 0.000 | |||
| BUN | 18–30 | 26 | 2.00 | 0.000 | 1.880 | 0.164 |
| 31–40 | 18 | 2.06 | 0.236 | |||
| 41 and above | 6 | 2.17 | 0.408 |
*Significance, if present, is in favor of the category with the highest arithmetic mean, *Correlation is significant at p < 0.001.
A total of 50 sputum samples were cultured on “Sabouraud dextrose agar (SDA) with chloramphenicol” antibiotic to prevent the growth of a variety of Gram-positive and Gram-negative bacteria (Fig. 2a–c). After one week of incubation at 25 °C, the majority of the samples (35 cultures) recorded positive growth, while 15 cultures recorded negative growth (Table 5). Moreover, some of the positive cultures are then stained with “Crystal Violet” and examined under the microscope. Figure 2d shows a single or cluster of oval-shaped cells with budding characteristics, indicating a unicellular fungus. However, further studies should be performed to identify the specific type.
Table 5: Fungal culture test of Cannabis and amphetamine abuser’s sputum samples on Sabouraud dextrose agar (SDA).
| COUNT | % | ||
|---|---|---|---|
| SDA | Positive | 35 | 70 |
| Negative | 15 | 30 | |
Discussion
Amphetamine and cannabis are frequently abused substances, and experimental evidence shows that cannabis use is associated with negative risks for non-medical amphetamine users22. The purpose of this cross-sectional study is to assess the effects of cannabis and amphetamines on various sociodemographic and biochemical characteristics in individuals who abuse, specifically in the Qassim region of Saudi Arabia, and may not be generalizable to other populations due to cultural, environmental, and genetic differences that can influence substance abuse patterns and health outcomes.
The sociodemographic variables of the 50 amphetamine plus cannabis abusers’ participants in this study (Table 1). For age, it is noticed that the majority, about half (52%), were 18–30 years of age, fewer (36%) were 31–40 years of age, and only 12 percent were above the age of 41 years. Most of the abusers (56%) are in secondary school-level education; a few (14%) were in preparatory school, and a few (4%) were in elementary school, whereas 26 percent were college-educated. It may suggest that adolescents often experiment with drugs due to rapid physical and intellectual development, which can be influenced by life events and social group affiliations, leading to an experimental attitude and increased drug use risk23–25.
A significant difference was observed in the employee ratio, where a considerable number of abusers are unemployed. Our findings are supported by a previous study26 that revealed that people who were jobless and had the lowest degree of education were more likely to be heavy drinkers, smokers, and physically inactive. Other variables of the present study were whether the participants had other health issues, and the majority of the answers were no. Lastly, the number of years of abuse that constituted 50 percent were from 5 to 10 years, slightly less (32%) was less than 5 years, and just 18% were drug abusers for more than 10 years.
Chronic abuse of amphetamine can cause a decrease in RBC count and hemoglobin levels due to drug-induced stress on the body. In contrast, cannabis abuse has been shown to have minimal effects on blood indices. Some studies have reported slight decreases in RBC count and hemoglobin levels, but these changes are usually within the normal range and not clinically significant4,5,20. Our results are consistent with these studies showing the possible negative consequences of drug misuse on immunity. As shown in Table 2, there were significant changes in different leukocyte blood types, including neutrophils (NE; p value = 0.001), lymphocytes (LYM; p value = 0.001), monocytes (MON; p value = 0.002), eosinophils (EO; p value = 0.001), and basophils (BASO; p value = 0.001). Additional research revealed that the immunosuppressive effects of drug compounds could not be directly attributable to the drugs’ effects on immune cells but rather may be explained by the production of endogenous immunomodulatory chemicals such as cytokines, free radicals, etc.4–11,11–27.
In addition, the microscopic view of blood film for patients who abuse the mixing drugs “Amphetamine and Cannabis”, shows segmented neutrophils with toxic change (Fig. 1B,C) have chromatin that is uneven and less condensed in the lobes, as well as a large number of large purple or dark blue cytoplasmic granules (primary granules) brought on by the retention of ribosomal RNA and cytoplasmic vacuolization. As opposed to their abnormal counterparts, normally matured segmented neutrophils in Fig. 1A (control) possess comparatively small nuclei, chromatin that is densely packed, and white cytoplasm with a majority of fine pink secondary granules. The exact cause of neutrophil toxicity is not fully understood, but several theories include direct toxic effects on bone marrow cells, activation of the immune system, and abnormal maturation of neutrophils. These effects can lead to nuclear granulation, which is not exclusive to cannabis and amphetamine abuse but can also occur in other conditions like infections and autoimmune diseases. Cytokines, primarily correlated with C-reactive protein, can cause toxic changes in neutrophils. Furthermore, it may be suggested that it is due to oxidative stress, which is characterized by the release of excess free radicals, reactive oxygen species, and cytokines and can lead to neutrophil cell destruction, causing cytotoxicity28,29.
Amphetamine abuse has been associated with liver damage, primarily due to the increased release of stress hormones and oxidative stress caused by the drug. Prolonged amphetamine abuse can lead to hepatotoxicity, characterized by elevated liver enzymes such as alanine aminotransferase (ALT) and aspartate aminotransferase (AST). Cannabis abuse, on the other hand, has shown conflicting results in terms of its effects on the liver profile. Some studies suggest a minor increase in liver enzymes, such as ALT and AST, in cannabis users. However, these changes are typically mild and not associated with severe liver damage30. Our results suggest no significant difference was observed in AST-GOT, ALT-GPT, and alkaline phosphatase levels, as depicted in Table 3, further validating the previously reported results30.
Amphetamine abuse has been linked to kidney damage, largely due to its vasoconstrictive effects and increased release of stress hormones. Long-term abuse of amphetamines can lead to renal impairment, characterized by elevated serum creatinine levels and a decreased glomerular filtration rate (GFR). In contrast, cannabis abuse has shown a limited impact on the kidney profile. Studies have been inconclusive, with some reporting a potential association between long-term cannabis use and mild kidney dysfunction, while others have found no significant effects31. Further validate our finding that neither creatinine nor blood urea nitrogen (BUN) levels were significantly affected among abusers (Table 3).
It is alarming to see that, in a fungus culture test using sputum samples from amphetamine and cannabis users, the majority of the samples (35 cultures) showed positive growth while just 15 cultures showed negative growth. Additionally, a few of the positive colonies are later stained with “Crystal Violet” and put under a microscope for inspection. A single or group of oval-shaped cells with budding features is seen in Fig. 2d; this is an example of a unicellular fungus that may suggest that due to the suppressed immunity, observed with blood results in opportunistic pathogens like yeast and mold inhabiting the upper respiratory tract of these chronic immunocompromised patients of drug abuse. However, further studies should be performed to identify the specific type. Our finding further validates the concept of "fungal priority pathogens", published by WHO recently (2022) which includes 19 groups of fungal pathogens that cause high-risk morbidity and mortality and aims to direct research to increase public health measures against invasive fungal diseases (IFDs)21.
The research aims to improve drug abuse research, diagnostics, treatment, and public health. It highlights that chronic amphetamine abuse has more severe effects on blood indices, liver profile, and kidney profile than cannabis abuse. However, individual variations in drug abuse patterns and susceptibility may influence these effects.
Conclusion
This study explores the immune system and hematological disturbances linked to amphetamine and cannabis abuse, providing insights into health risks and targeted interventions. The findings complement previous research on drug users’ hematological abnormalities, particularly neutrophil cytotoxicity in differential white blood counts. Routine hematological tests (CBC) help identify alterations in homeostatic conditions, improving patient knowledge and preventing major issues, may suggest specific screening protocols or monitoring strategies for individuals known to abuse these substances. The multifaceted approach needed to address substance abuse effectively in future research targeted multi-drug abuse prevention, early detection, and intervention. Addressing the limitation of the present study with a larger sample size with the addition of a control group in the study could further enhance the study’s outcomes.
At present this cross-sectional design allows for a snapshot of the immune system and hematological status among abusers, laying the groundwork for future longitudinal research studies, that would allow for the assessment of long-term effects of substance abuse on the immune system and hematological parameters, providing insights into the progression of potential health issues and the effectiveness of the intervention. Besides the potential policy implications and efforts to combat drug abuse by the Saudi Government, there is a need to have more stress on drug education programs and support services for substance abusers.
References
- 1.The kingdom to celebrate the International Day Against Drug Abuse and Illicit Trafficking. Ministry of Health Saudi Arabia. https://www.moh.gov.sa/en/Ministry/MediaCenter/News/Pages/News-2014-06-29-001.aspx.
- F Alasmari, MA Assiri, SR Ahamad. Serum metabolomic analysis of male patients with cannabis or amphetamine use disorder. Metabolites, 2022. [DOI | PubMed]
- IM Attafi, MM Tumayhi, D Banji, MY Albeishy, IA Khardali, HM Korashy. Analysis of fatalities involving amphetamine in Jazan, Saudi Arabia. Forensic Sci. Int. Rep., 2021. [DOI]
- O Alshaarawy. Total and differential white blood cell count in cannabis users: Results from the cross-sectional National Health and Nutrition Examination Survey, 2005–2016. J. Cannabis Res., 2019. [DOI | PubMed]
- D Guzel, AB Yazici, E Yazici, A Erol. Alterations of the hematologic cells in synthetic cannabinoid users. J. Clin. Lab. Anal., 2017. [DOI | PubMed]
- F Tavasolian, E Abdollahi, M Samadi, M Vakili. Analysis of hematological and biochemical parameters in methamphetamine addicts compared with healthy individuals. Med. Lab. J., 2015. [DOI]
- Y Zhang, G Shu, Y Bai, J Chao, X Chen, H Yao. Effect of methamphetamine on the fasting blood glucose in methamphetamine abusers. Metab. Brain Dis., 2018. [DOI | PubMed]
- NR Sharma, B Sharma, S Lamichhane, M Pokhrel, S Gautam. A case of ecstasy-induced acute hepatic injury. Cureus, 2022. [DOI | PubMed]
- A Amanollahi, Y Mehrabi, M Sedighi. Assessment of renal function indexes in methamphetamine or tramadol intoxication adults to the emergency departments: A systematic review and meta-analysis. BMC Emerg. Med., 2023. [DOI | PubMed]
- A Kazory, R Aiyer. Synthetic marijuana and acute kidney injury: An unforeseen association. Clin. Kidney J., 2013. [DOI | PubMed]
- RS Alharbi, AH Alhowail, AG Alharbi, AM Emara. Evaluation of the health status outcome among inpatients treated for amphetamine addiction. Saudi J. Biol. Sci., 2022. [DOI | PubMed]
- W Glac, J Dunacka, B Grembecka, G Świątek, I Majkutewicz, D Wrona. Prolonged peripheral immunosuppressive responses as consequences of random amphetamine treatment, amphetamine withdrawal and subsequent amphetamine challenges in rats. J. Neuroimmune Pharmacol., 2021. [DOI | PubMed]
- 13.World Health Organization. (n.d.). Cannabis. World Health Organization. https://www.who.int/teams/mental-health-and-substance-use/alcohol-drugs-and-addictive-behaviors/drugs-psychoactive/cannabis.
- C Dong, J Chen, A Harrington, KY Vinod, ML Hegde, VL Hegde. Cannabinoid exposure during pregnancy and its impact on immune function. Cell Mol. Life Sci., 2019. [DOI | PubMed]
- SB Maggirwar, JH Khalsa. The link between cannabis use, immune system, and viral infections. Viruses, 2021. [DOI | PubMed]
- DG Deavall, EA Martin, JM Horner, R Roberts. Drug-induced oxidative stress and toxicity. J Toxicol., 2012. [DOI | PubMed]
- PD Ray, BW Huang, Y Tsuji. Reactive oxygen species (ROS) homeostasis and redox regulation in cellular signaling. Cell Signal., 2012. [DOI | PubMed]
- 18.Aird, W. Toxic granulation the blood project. The Blood Project. https://www.thebloodproject.com/toxic-granulation/ (2022).
- 19.Clinical drug testing in primary care – substance abuse and mental … (n.d.-a). https://store.samhsa.gov/sites/default/files/d7/priv/sma12-4668.pdf.
- J Raka, G Aishwariya Brigit, N Shubham. Hematological changes in alcohol and substance use disorders: An overview. Int. Arch. Subst. Abuse Rehabil., 2020. [DOI]
- MC Fisher, DW Denning. The WHO fungal priority pathogens list as a game-changer. Nat. Rev. Microbiol., 2023. [DOI | PubMed]
- D Daldegan-Bueno, LO Maia, M Glass, D Jutras-Aswad, B Fischer. Co-exposure of cannabinoids with amphetamines and biological, behavioral and health outcomes: A scoping review of animal and human studies. Psychopharmacology (Berlin), 2022. [DOI | PubMed]
- AN Mahsoon, L Almashat, N Alsubaui, S Hindi, S Alharbi, S Yaghmour, L Sharif. Socio-demographics of initial substance use exposure and its relation to progression: A cross-sectional study in Saudi Arabia. Cureus, 2023. [DOI | PubMed]
- AI Al-Haqwi. Perception among medical students in Riyadh, Saudi Arabia, regarding alcohol and substance abuse in the community: A cross-sectional survey. Subst. Abuse Treat. Prev. Policy, 2010. [DOI]
- L Lander, J Howsare, M Byrne. The impact of substance use disorders on families and children: From theory to practice. Soc. Work Public Health, 2013. [DOI | PubMed]
- M Plessz, S Ezdi, G Airagnes, I Parizot, C Ribet, M Goldberg, M Zins, P Meneton. Association between unemployment and the co-occurrence and clustering of common risky health behaviors: Findings from the Constances cohort. PLoS ONE, 2020. [DOI | PubMed]
- DC Vidot, JA Manuzak, NR Klatt. Brief report: Hazardous cannabis use and monocyte activation among methamphetamine users with treated HIV infection. JAIDS J. Acquired Immune Defic. Syndr., 2019. [DOI | PubMed]
- A Van de Vyver, EF Delport, M Esterhuizen, R Pool. The correlation between C-reactive protein and toxic granulation of neutrophils in the peripheral blood. SAMJ S. Afr. Med. J., 2010. [DOI | PubMed]
- G Pizzino, N Irrera, M Cucinotta, G Pallio, F Mannino, V Arcoraci, F Squadrito, D Altavilla, A Bitto. Oxidative stress: Harms and benefits for human health. Oxid. Med. Cell Longev., 2017. [DOI | PubMed]
- L Karila, P Roux, B Rolland. Acute and long-term effects of cannabis use: A review. Curr. Pharm. Des., 2014. [DOI | PubMed]
- S Dellepiane, I Paranjpe, M Rajagopal. Cannabis use and CKD: Epidemiological associations and Mendelian randomization. Kidney Med., 2023. [DOI | PubMed]
